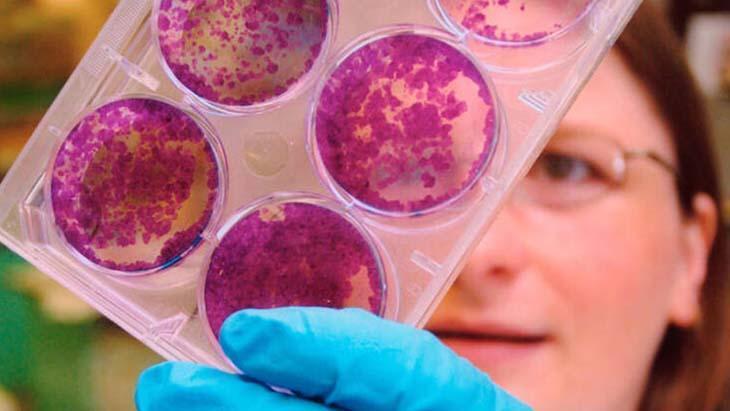
Memedeki kitlede ağrı varsa kesinlikle kanser değildir

Erkeklerde meme kanseri görülür mü? İşte meme kanseriyle ilgili doğru bilinen yanlışlar
28.09.2020 - 13:13 | Son Güncellenme:
Her yıl dünyada yaklaşık 2 milyon, Türkiye’de ise 20-25 bin kadına meme kanseri teşhisi konuluyor. Ülkemizde yaşamı boyunca her 22-23 kadından birinde meme kanseri görülüyor ve 6 meme kanseri hastasından birinin 40 yaşın altında olduğu gözlemleniyor. Bununla birlikte her 100 meme kanseri hastasından birinin de erkek olduğu biliniyor. Tüm bu veriler, meme kanserinin dünyada ve ülkemizde hızla yayıldığını ortaya koyuyor. Bu durumda meme kanseri konusunda farkındalığın artması her geçen gün daha fazla önem kazanıyor. Prof. Dr. Fatih Aydoğan, meme kanseri ile ilgili toplumda doğru bilinen çok sayıda yanlış olduğunu belirterek, bu konuda bilinçlenmenin önemine dikkat çekti.

“Ailesinde meme kanseri öyküsü olmayan kişide meme kanseri görülmez”
Birçok insan meme kanserinin tamamen ailesel geçişli olduğunu düşünür. Ancak meme kanseri tanısı alan hastaların önemli bir çoğunluğunda aile öyküsü bulunmamaktadır. Ailevi ya da genetik geçişli meme kanserleri, tüm meme kanserlerinin sadece %15-20’sini oluşturur.
"Memedeki kitlede ağrı varsa kesinlikle kanser değildir"
Meme kanserinde en sık bulgu, ağrısız kitledir. Ancak hastaların %10-20’sinde kitleye ağrı eşlik edebilir. Kişide ağrı olup olmaması kitlenin öneminin belirlenmesinde bir ölçüt değildir. Kitle varlığı durumunda klinik muayene ve görüntüleme tetkiklerinin sonuçlarına göre karar verilmelidir.

"Memede kitle yoksa kanser yoktur"
Meme kanserinin kitle dışında başka bulguları da olabilir. Meme derisinde ya da ucunda içeri çökme, meme derisinde kalınlaşma, meme başı akıntısı, koltuk altında kitle olması meme kanserinin diğer bulguları arasındadır. Taramada görülen meme kanserleri kitle haline gelmeden saptanabilmektedir.

“Genç yaşta mamografi çekilmez"
Meme kanseri konusunda herhangi bir belirtisi olmayan sağlıklı bir kadında tarama amaçlı mamografi çekimine 40 yaşından sonra başlanmalıdır. Ancak kitle veya benzeri bulguların varlığında ya da meme kanseri şüphesinde daha erken yaşta yapılabilir. Bu konudaki bilimsel kılavuzlar, ailesinde meme kanseri öyküsü olan bir kadın için ilk mamografi tarama zamanının ailedeki bireyin meme kanseri tanı yaşından 10 yıl önce olmasını önermektedir.

“Meme kanseri gençlerde görülmez”
Meme kanseri riski yaşla birlikte artmasına rağmen erken yaşta da görülebilmektedir. Türkiye’de meme kanseri ortalama yaşı ABD’ye göre 11 yıl daha erkendir. Ülkemizde meme kanseri tanısı alan her 6 kadından biri 20’li ve 30’lu yaşlardadır.

“Meme kanserli hastalarda iki meme alınırsa hastalık tekrar etmez ve ek tedaviye ihtiyaç olmaz”
Genetik geçişli meme kanserlerinde ve yoğun aile öyküsünde, diğer memeye de risk azaltıcı cerrahi yapılabilmektedir. Ancak iki memenin de alınması, meme kanserinin tekrar etme riskini sıfıra indirmemektedir. Meme kanseri sistemik bir hastalık olduğu için, cerrahiye ek olarak ilaç ya da ışın tedavisi tamamlayıcı olarak gerekebilmektedir.

"Meme kanseri tedavisi gören kadınlar bir daha çocuk sahibi olamaz"
Meme kanseri tedavisi gerçekleştirilen uygun hastalarda hekim onayı ile gebeliğe izin verilebilmektedir. Kemoterapi başlanmadan önce de tüp bebek teknikleriyle yumurta ya da embriyo dondurma işlemleri gebelik şansını artırmak için kullanılabilmektedir.

“Sıkı ve balenli sütyenler meme kanseri riskini artırır”
Toplumda, sütyen kullanımının meme kanserine sebep olabileceği konusunda kulaktan dolma bilgiler yayıldığı görülmektedir. Sutyendeki balenlerin meme dokusuna baskı yapması ile lenf akımını engellediği teorisi ileri sürülse de, meme kanseri ve sütyen kullanımı ile ilişkili bilimsel bir kanıt bulunmamaktadır.

“Kitlelere biyopsi yapılması meme kanserinin yayılmasına sebep olur”
Memedeki şüpheli kitlelerin tanısı için iğne biyopsileri kullanılmaktadır. Biyopsilerin kanser yayılımına sebep olduğu ile ilgili bilimsel bir kanıt bulunmamaktadır. İğne biyopsisi sonucunda iyi huylu çıkan kitlelerde ameliyata gerek kalmazken, meme kanseri tanısı alan hastalarda biyopsi ile tümörün alt tipi belirlenerek tedavi planı yapılmaktadır. Bu nedenle biyopsi meme kanseri tedavisine yön veren çok önemli bir uygulamadır.

“Erkeklerin memesi olmadığı için kanser görülmez”
Erkeklerde meme dokusu kadınlara göre daha az olsa da meme kanseri erkeklerde de ortaya çıkabilmektedir. Her 100 meme kanseri hastasından bir tanesi erkektir. Erken tanı ve tedavi planlaması ile erkeklerde de meme kanseri kısa sürede kontrol altına alınabilmektedir.












